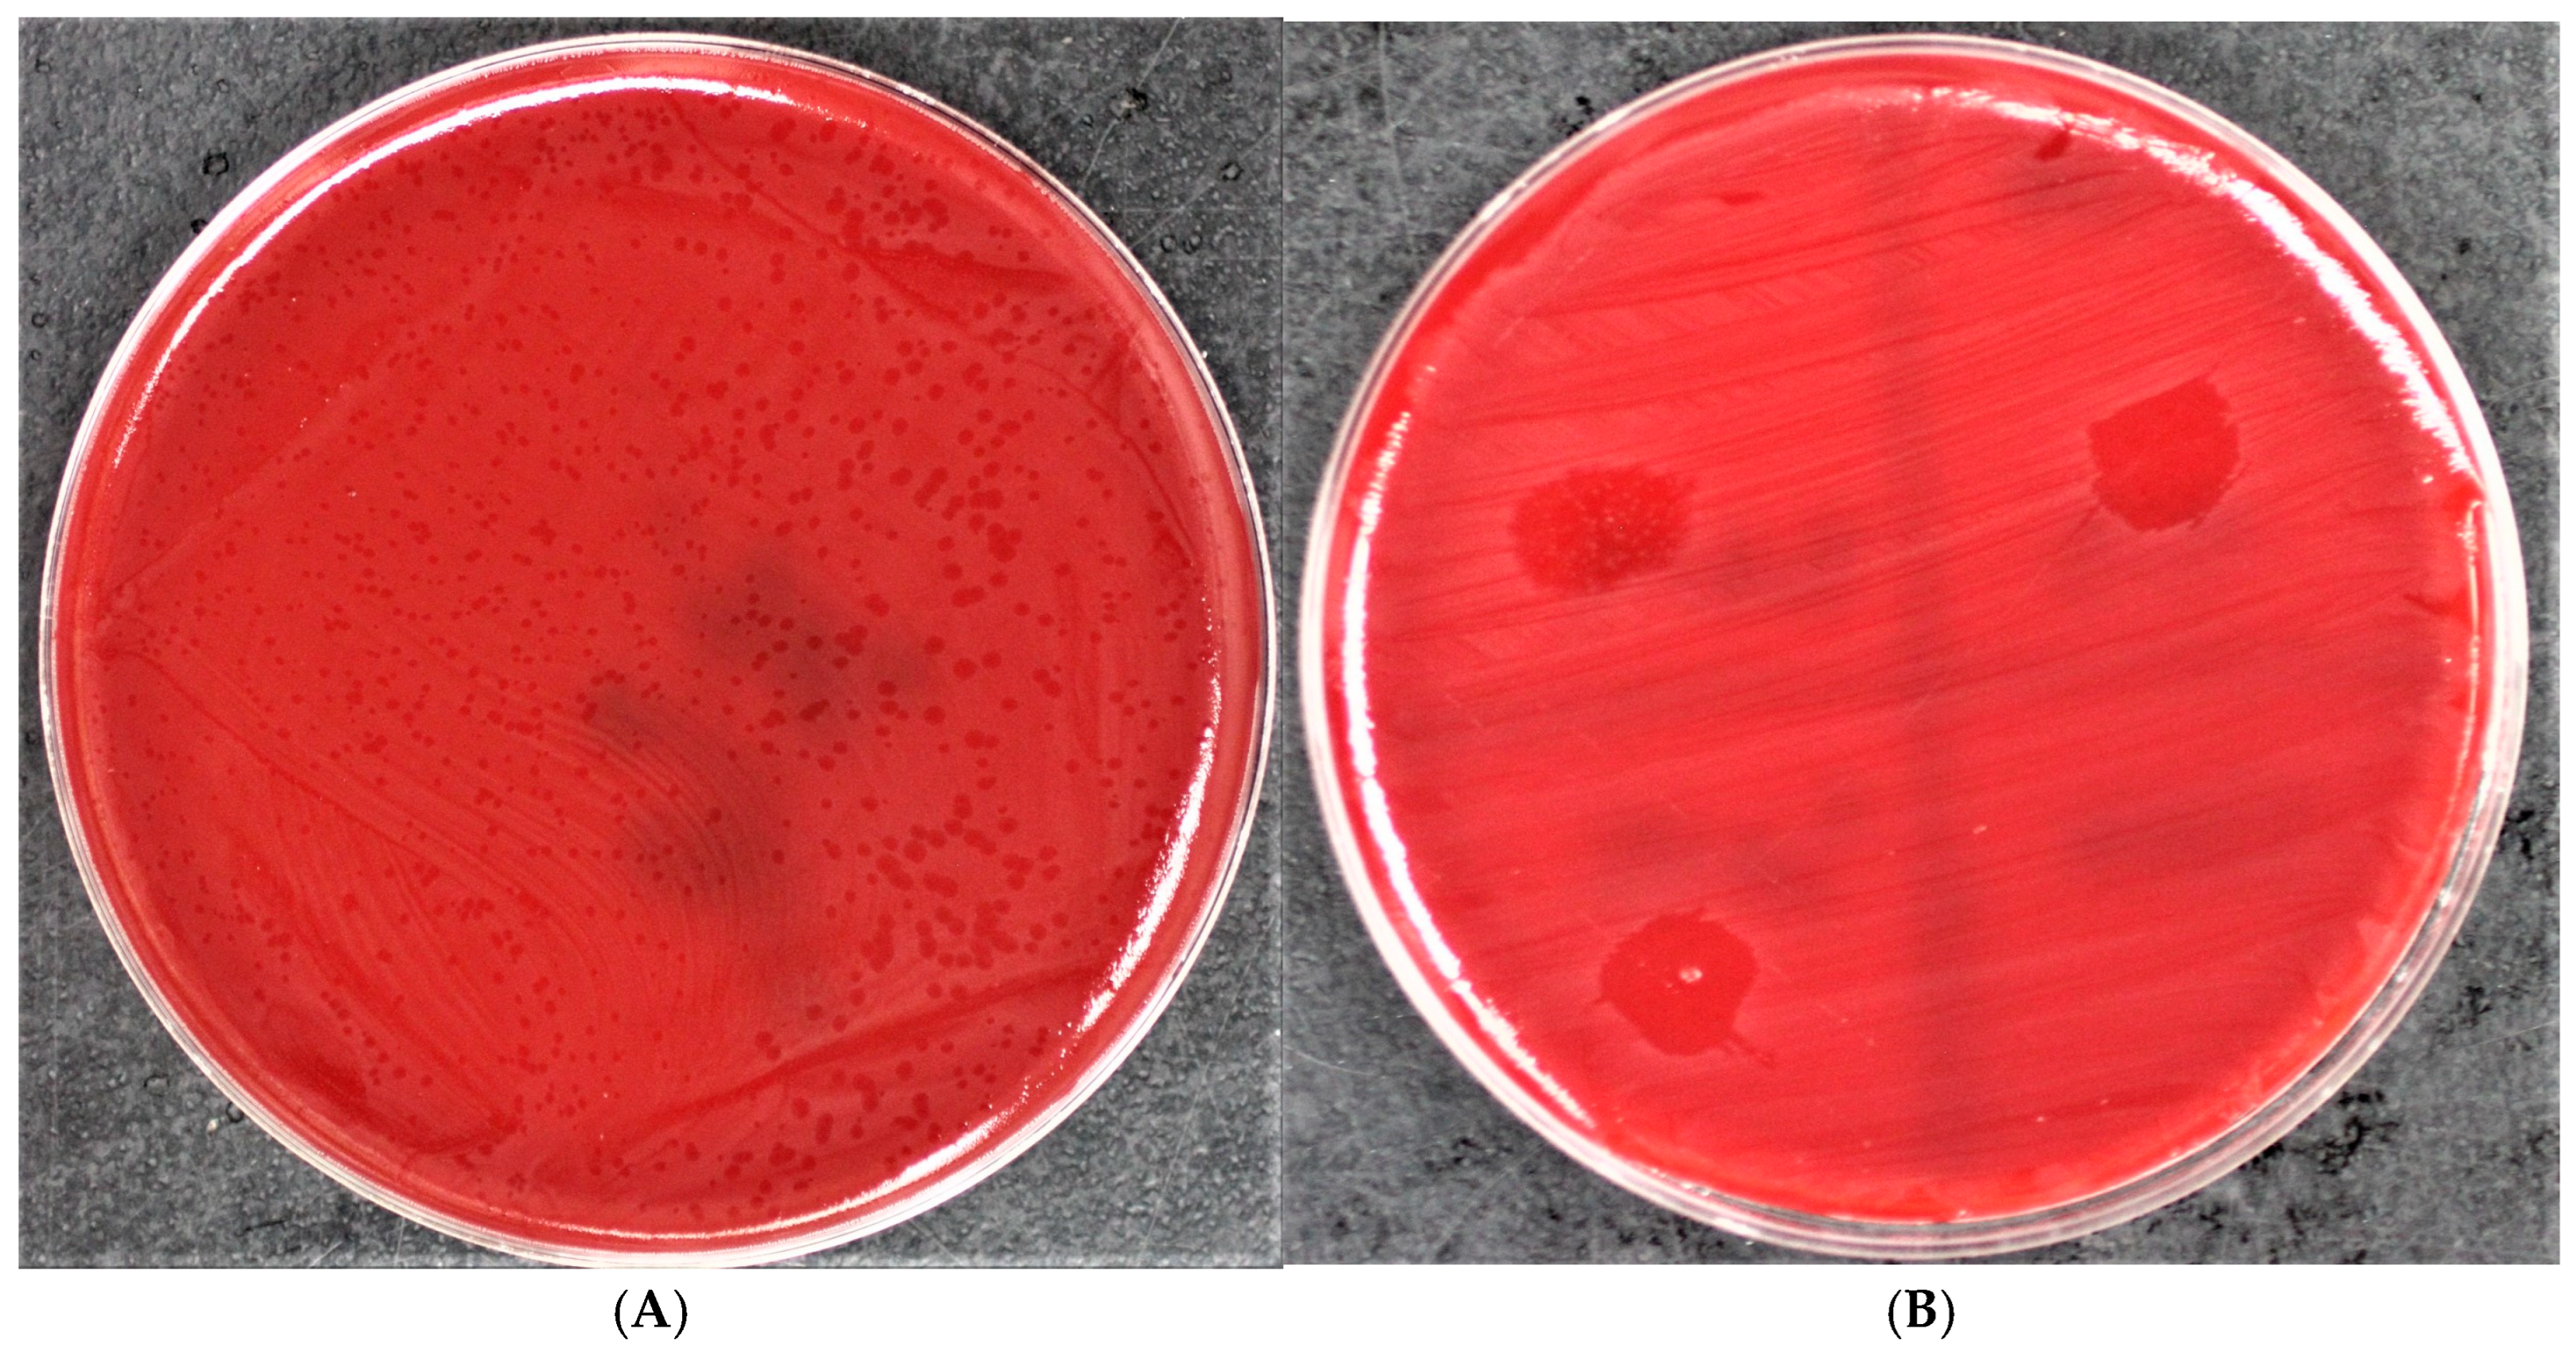
Applbiosci 04 00010 g001

Abstract
Fusobacterium necrophorum subspecies necrophorum, a resident of the rumen, is the causative agent of bovine liver abscesses. Currently, tylosin, a macrolide, is used in the feed to reduce liver abscesses. Because macrolides are medically important antibiotics, their use in food animal production is of public health concern. There is significant interest in finding antimicrobial alternatives. Bacteriophages that lyse subsp. necrophorum have the potential to replace tylosin. Our objective was to isolate bacteriophages lytic to subsp. necrophorum. Pooled ruminal fluid from slaughtered cattle and pooled sewage samples were collected and incubated overnight with lysine, and subsp. necrophorum strains and filtrates were spotted on F. necrophorum lawns. Phage plaques were harvested and purified. Bacteriophage isolation frequencies were compared between sample types, sampling dates, and necrophorum strains. Overall relative frequency of isolated bacteriophages lytic to subsp. necrophorum was 17.1%. The frequency of bacteriophage isolation ranged from 0 to 25.4% for ruminal fluid, and from 13.7 to 32.0% for sewage. Isolation frequency was significantly higher in sewage than in ruminal fluid samples (p < 0.01). Isolation rates varied significantly between necrophorum strains. Sewage was a rich source of bacteriophages lytic to necrophorum, which have the potential to be used to prevent liver abscesses.
1. Introduction
Liver abscesses lead to liver condemnations in beef cattle slaughter plants, accounting for 58% of all condemned livers in the US [1]. In addition, liver abscesses, particularly severe abscesses (multiple small- to medium-sized abscesses and one or more large abscesses), have a negative impact on growth performance and carcass yield, and labor and time associated with handling carcasses [2]. The major causative agent is Fusobacterium necrophorum, an anaerobic and Gram-negative, rod-shaped opportunistic pathogen [3] that resides in the rumen as a member of the bacterial community and penetrates the ruminal epithelium to enter the portal circulation and then to the liver to induce abscesses. The penetration is facilitated by chronic ruminal acidosis in beef cattle fed energy-dense, high-grain diets, which damage the ruminal epithelium and permit F. necrophorum to enter the ruminal wall to cause microabscesses and rumenitis. These microabscesses serve as the source for the F. necrophorum to enter the portal blood and then on to the liver to initiate infection to cause abscesses [2]. Two subspecies, necrophorum and funduliforme, are reported, which differ in colony and cell morphologies, growth patterns in broth, and, more importantly, in virulence [4]. The subsp. necrophorum is more virulent; hence, it is more frequently involved in liver abscesses than the subsp. funduliforme [5].
Currently, tylosin phosphate is used as an in-feed supplement to reduce the incidence of liver abscesses [2]. The use of in-feed tylosin is a public health concern because the antibiotic, although used exclusively in animals, belongs to the macrolide class of antibiotics, which are considered medically important. Consequently, there is significant interest in seeking antibiotic alternative approaches to replace the use of tylosin. Bacteriophages are viruses that infect bacteria and are either lytic or lysogenic. Originally, phages were investigated as potential therapeutic agents against human and animal infections [6]. In recent years, the therapeutic use of phages, or phage therapy, has regained interest as an alternative to traditional antibiotic therapy [7,8,9,10,11].
Bacteriophages have been successfully used in food animal processing plants to control for foodborne pathogens, such as Shiga-toxin-producing E. coli [12]. Although F. necrophorum is a major bovine pathogen, there is only one report on the isolation of bacteriophages lytic to this bacterium [13]. However, bacteriophages have been isolated from other species of Fusobacterium, such as nucleatum, a human oral pathogen, and varium, a human and animal pathogen [14,15]. Lytic phages, as opposed to lysogenic phages, will have therapeutic application in reducing or eliminating F. necrophorum in the rumens of cattle. Based on culture-based analysis of purulent materials of liver abscesses, almost 100% of liver abscesses contain F. necrophorum, suggesting that controlling this pathogen would be the logical approach to control liver abscesses [16]. Our primary objective was to isolate bacteriophages that are lytic to subsp. necrophorum. Here, we report on the relative frequency of isolation of bacteriophages lytic to F. necrophorum subsp. necrophorum from ruminal fluid and city sewage samples.
2. Materials and Methods
2.1. Fusobacterium necrophorum Strains
A total of 68 F. necrophorum subsp. necrophorum strains, previously isolated from liver abscesses of beef cattle [16], were used for bacteriophage detection and isolation. Of the 68 strains, 65 were used for bacteriophage isolation from ruminal fluid and 56 were used for isolation from city sewage samples. Fifty-three strains were used for both sample types, while 12 strains were used for phage isolation from ruminal fluid samples only, and 3 were used for isolation from city sewage samples only. The strains, stored at −80 °C, were streaked onto blood agar plates (Remel Inc., Lenexa, KS, USA) and incubated at 37 °C for 48 h in an anaerobic glove box (Forma Scientific Inc., Marietta, OH, USA). Single colonies of each strain were inoculated into 10 mL pre-reduced (with 0.05% cysteine HCl; Sigma-Aldrich, St. Louis, MO, USA), anaerobically sterilized brain heart infusion broth (PRAS-BHI; Becton Dickinson, Sparks, MD, USA) and incubated overnight at 37 °C.
2.2. Collection of Ruminal Fluid and City Sewage Samples
Ruminal fluid samples were collected at a beef cattle packing plant in the Midwest on five different dates. At each visit, over a period of 4 to 6 h, 3 L of pooled ruminal fluid collected from squeezed ruminal contents from cattle originating from at least five different feedlots were collected. Ruminal fluid was transported to the laboratory on ice in tightly capped thermos containers. Sewage samples were collected at a wastewater treatment plant in the city of Manhattan, KS, USA, on five different dates. At each visit, 3 L of untreated sewage samples were collected and transported to the laboratory. Ruminal fluid and sewage samples were kept in a refrigerator and processed the next day for bacteriophage isolation.
2.3. Isolation of Bacteriophages
One hundred milliliters of either ruminal fluid or sewage samples were aliquoted into twelve 125 mL flasks, supplemented with 0.73 g L-lysine (Sigma-Aldrich, Burlington, VT, USA) [17] and 3.7 g of dehydrated BHI powder (Beckton Dickinson, Franklin Lakes, NJ, USA). The flasks were placed in an anaerobic glove box, and 1 mL each of overnight broth cultures of three to five randomly selected F. necrophorum strains were inoculated into each flask, followed by an overnight incubation at 37 °C with constant shaking. Following incubation, 1 mL from each flask was pipetted into an Eppendorf tube (Eppendorf AG, Hamburg, Germany) and centrifuged at 12,000× g rcf for 2 min. Five hundred microliters of the resulting supernatant were then pipetted into each of two 2 mL Spin-X microcentrifuge tubes (Corning Costar, Corning, NY, USA) with a 0.22 µm membrane filter and centrifuged at 12,000× g rcf for 2 min. Flow-through from the Spin-X tubes was pipetted into a 0.22 µm syringe filter and filtered a second time. Twenty microliters of this filtrate were then diluted in 180 μL of sterile SM buffer (G-Biosciences, St. Louis, MO, USA) in a 1.5 mL Eppendorf tube to create a 1:10 dilution. Individual bacterial cultures were spread-plated on blood agar plates using sterile cotton swabs to obtain bacterial lawns, and 20 µL of the corresponding flask filtrates and filtrate dilutions were spotted onto each plate. The plates were placed in an anaerobic glove box and incubated at 37 °C overnight. The following day, the bacterial lawns were checked for zones of bacterial lysis or plaques (Figure 1A). A phage plaque is a clearing in a bacterial lawn formed by outward diffusion of phage virions [18]. The zones of lysis were harvested as agar plugs using a sterile transfer pipette, and eluted in 500 µL sterile SM buffer in 1.5 mL Eppendorf tubes overnight at 37 °C in an anaerobic glove box. Following overnight elution, tubes were centrifuged for 30 s at 12,000× g rcf, and the supernatant was transferred to a sterile Spin-X tube with a 0.22 µm filter and centrifuged at 12,000× g rcf for 2 min.
Figure 1.
Bacteriophage plaques (A) and zones of bacterial lysis (B) observed on Fusobacterium necrophorum subspecies necrophorum lawns.
2.4. Bacteriophage Purification
Bacteriophage filtrates, previously harvested from zones of bacterial lysis, were serially diluted 10-fold in SM buffer, and 100 μL of each dilution was mixed with 100 μL of the corresponding F. necrophorum strain used for initial bacteriophage isolation, then spread-plated onto blood agar plates. Inoculated plates were incubated overnight at 37 °C in an anaerobic glovebox. Bacterial lawns were checked for the presence of single, well-isolated plaques (Figure 1B), which were then harvested as described above. If multiple plaque morphologies were observed, each morphologically different plaque was harvested separately. This bacteriophage purification process was repeated twice, and 100 µL of purified bacteriophage lysate was then distributed into two cryovials, each containing 300 µL 20% glycerol, and stored in a −80 °C freezer.
2.5. Statistical Analysis
The frequency of F. necrophorum bacteriophage isolation was estimated as the proportion of samples positive for the presence of bacteriophage divided by the total number of F. necrophorum strains tested. Descriptive statistics were obtained for each strain per sample type. Relative frequencies were determined by dividing the number of isolated bacteriophages by the total number of samples. The frequency of isolation was determined for sample collection dates, pooled ruminal and sewage samples, pooled total samples, and individual F. necrophorum strains. The results were analyzed using STATA v. 16.1 (Stata Corp, College Station, TX, USA). Prevalences of bacteriophage were stratified by sample type, sampling day, and F. necrophorum strains used for isolation. Crude associations between frequency of sample type or sampling date were tested via the likelihood-ratio based chi-square test or the Fisher’s exact test. Bacteriophage isolation results (presence or absence) were considered as the outcome variable. Multivariable random effects logistic regression models were fitted to test associations between isolated bacteriophages and sample types or sampling days, while accounting for clustering by F. necrophorum strain identifier to address the lack of independence associated with testing F. necrophorum strains on multiple sampling days. All possible two-way interactions between individual explanatory variables were assessed at significance level p < 0.05. The Wald chi-square test was used to assess the statistical significance of association between the outcome and each explanatory variable or two-way interaction between variables. An explanatory variable or two-way interaction between variables was considered significant at p-value < 0.05.
3. Results
A total of 68 strains of F. necrophorum subsp. necrophorum were tested with ruminal fluid and city sewage samples collected on five separate dates for the detection and isolation of lytic bacteriophages. The number of F. necrophorum strains used in each collection ranged from 47 to 59 and 50 to 53 for ruminal fluid and city sewage samples, respectively. Overall, 89 bacteriophages lytic to F. necrophorum subsp. necrophorum were isolated from five different sampling days from both sample types using 65 strains of F. necrophorum subsp. necrophorum. The frequency of bacteriophage isolation differed between sample types, with ruminal fluid sample isolation frequencies ranging from 0 to 25.4% and sewage sample frequencies ranging from 13.7 to 32.0% (Table 1). Bacteriophage isolation frequency of lytic F. necrophorum subsp. necrophorum bacteriophages was significantly higher in city sewage samples compared to bovine ruminal fluid samples (p < 0.0001). Furthermore, relative isolation rates of bacteriophages from sewage had a 0.9 log odds increase compared to isolation rates of bacteriophages from ruminal fluid (p < 0.0001). There were no differences in relative isolation rates between sewage collection dates (p = 0.2909), but differences in isolation rates between ruminal fluid collection dates were significant (p = 0.0091).
Table 1.
Relative frequency of bacteriophage isolations from bovine ruminal fluid and city sewage samples with Fusobacterium necrophorum subsp. necrophorum strains of liver abscess origin.
The frequency of bacteriophage isolation varied among different strains of F. necrophorum subsp. necrophorum (Table 2 and Table 3). Of the 65 strains used with ruminal fluid, 22 strains yielded bacteriophages and 43 did not. Regarding sewage samples, 26 strains did not yield bacteriophages, while 33 strains did, and 3 of these 33 strains yielded bacteriophages at each collection date (Table 2). Overall, 40 strains of F. necrophorum yielded bacteriophages with either ruminal fluid or sewage sample on one or more of the sampling dates (Table 3). Thirteen strains yielded bacteriophages from both ruminal fluid and sewage samples, whereas 8 strains yielded bacteriophages from only ruminal fluid and 17 strains yielded from sewage sample only (Table 4). The relative frequencies of bacteriophage isolation for three specific F. necrophorum subsp. necrophorum strains (2016-13-11, 2016-13-29, and 2016-13-69) were 60%, 60%, and 85.7%, respectively (Table 3). For two strains (2016-13-11 and 2016-13-29), the relative frequencies of isolating bacteriophages in bovine ruminal fluid and city sewage samples were 1/5 and 5/5 or 20% and 100%, respectively. The third strain (2016-13-69) had relative frequencies of isolating bacteriophages in bovine ruminal fluid and city sewage samples of 1/2 and 5/5 or 50% and 100%, respectively. Overall, the highest relative frequency of isolating bacteriophages was observed for the F. necrophorum subsp. necrophorum strain (2016-13-69) at 85.7% (5/7). None of the F. necrophorum subsp. necrophorum strains had a relative frequency of isolating bacteriophages over 50% from ruminal fluid, while nine strains had relative frequencies over 50%, three of which were 100%, from sewage samples.
Table 2.
Frequency of bacteriophage isolations from bovine ruminal fluid and city sewage samples with Fusobacterium necrophorum subsp. necrophorum strains of liver abscess origin.
Table 3.
Number of bacteriophages isolated from bovine ruminal fluid or city sewage samples with Fusobacterium necrophorum subsp. necrophorum strains of liver abscess origin on different sampling dates.
Table 4.
Number of bacteriophages isolated from bovine ruminal fluid or city sewage samples with Fusobacterium necrophorum subsp. necrophorum of liver abscess origin.
4. Discussion
Currently, the available method to control liver abscesses is the use of antimicrobial feed additives. Five antimicrobial compounds have FDA approval for use in the feed to control liver abscesses in the US, and the most widely used antibiotic is tylosin, which belongs to the macrolide class of antimicrobials [2]. Tylosin is a narrow-spectrum antibiotic, primarily effective against Gram-positive bacteria [19]. However, the antibiotic is inhibitory to certain Gram-negative bacteria, including F. necrophorum [20,21]. Although tylosin is used exclusively in animals, it is structurally similar to erythromycin, and antibiotics in the macrolide class are categorized as medically important because of their extensive use in human medicine [22]. Therefore, there is growing scrutiny in the use of tylosin in animals and it is under the Veterinary Feed Directive with veterinary oversight [23]. The impact of tylosin exposure on antimicrobial resistance of gut bacteria, particularly enterococci, which has the propensity for horizontal transfer of AMR genes, is of some concern [24,25,26]. In a recent study that measured the AMR of gut bacteria in feedlot cattle administered with in-feed tylosin to prevent liver abscesses, the conclusion was that the AMR impact was minimal and did not extend beyond an occasional increase in macrolide-resistant fecal enterococci [27]. Interestingly, there is no evidence of macrolide resistance in F. necrophorum isolated from liver abscesses of tylosin-fed cattle [16,28]. Because of the public health concern associated with the use of a medically important antibiotic in cattle diets, there is considerable interest in finding alternatives to replace tylosin. Some of the alternatives that have been evaluated include vaccines [29,30,31], essential oils [32,33,34], oil seeds [35], egg yolk immunoglobulins [36], and direct-fed microbials [37]. Because virulence factors have been identified and a few have been well characterized, there have been many efforts to develop an efficacious vaccine [38]. Although a bacterin (suspension of killed whole bacterial cells) is commercially available (Fusogard®; Elanco Animal Health, Greenfield, IN, USA), the efficacy of the vaccine has been shown to be marginal and has not replaced tylosin use in the feedlot industry [39]. Feeding with certain yeast-based commercial direct-fed microbial products has been shown to reduce the severity of liver abscesses compared to the control, although the proportion of total abscessed livers was not different [40]. The likely mode of action is the alleviation of ruminal acidosis by yeast products [41].
Virulent or lytic bacteriophages are a potential alternative to antimicrobials to treat animal and human infections [42,43]. Phage therapy was investigated in the 1920s and 1930s, but interest was lost as antibiotics became available [44]. In recent decades, there has been a renewed interest in phage therapy, as data show that it could be an effective tool against bacterial infections in animal and human medicine [45,46,47,48,49]. However, limited research has been conducted on phage therapy for pathogens in animals. The only study reported on the isolation of bacteriophages lytic to F. necrophorum was by Tamada et al. [13]. The study reported a single phage isolated and characterized from 54 bovine ruminal fluid samples. The phage was lytic to both subspecies of F. necrophorum [13].
In the phage isolation procedure, we used an enrichment step that included incubation of ruminal fluid or sewage samples with lysine and F. necrophorum strains (three to five strains per sample aliquot) in order to promote fusobacterial growth and enhance the likelihood of phage isolation. Fusobacterium necrophorum utilizes lysine as an energy source, which it rapidly deaminates and degrades to acetate, butyrate, and ammonia [17,50]. Therefore, the addition of lysine to ruminal fluid, and possibly sewage samples, enriches the fusobacterial population. A total of 68 F. necrophorum subsp. necrophorum strains were used in the enrichment step, and because the collection dates for the two sample types were different, the same number of strains was not used at each sampling time. It is evident that phages were detected more often with certain strains than others, which is not surprising because of the known host specificity of phages [51,52]. A major limitation of this study was that different collection dates had varying numbers, between 47 and 59, of F. necrophorum subsp. necrophorum strains used. This was due to the lack of viability of some bacterial strains at each collection date. There were no obvious patterns observed for bacterial viability throughout the study period. Also, for logistical reasons, collections of bovine ruminal fluid and city sewage sample were conducted in different seasons.
The finding that phages were isolated from city sewage samples, in addition to ruminal fluid, was not unexpected. Fusobacterium necrophorum is also a member of the normal bacterial community of the human throat, urogenital, and gastrointestinal tracts [53,54,55]. In humans, F. necrophorum is an opportunistic pathogen and causes pharyngotonsillitis, especially in adolescent and young adults, and in rare situations leads to an invasive infection called Lemierre syndrome [53,54,56,57]. The strains of F. necrophorum isolated from humans are more often subsp. funduliforme than subsp. necrophorum [57,58]. A surprising finding in our study was the higher frequency of isolation of phages from city sewage samples than from bovine ruminal fluid. There was approximately a twofold increase in the overall frequency of the isolation of bacteriophages lytic to F. necrophorum subsp. necrophorum from city sewage compared to ruminal fluid samples. The increased frequency of isolation from sewage samples is not surprising because raw sewage is composed of a complex microbial community and there is evidence that sewage has an abundant population of phages [59]. In summary, relative frequencies of bacteriophage isolation lytic to F. necrophorum subsp. necrophorum were higher in city sewage samples than bovine ruminal fluid.
5. Conclusions
This is the first study that has successfully isolated bacteriophages lytic to F. necrophorum subsp. necrophorum of bovine liver abscesses. Pooled ruminal fluid from slaughtered cattle and pooled sewage samples were utilized for the detection and isolation of lytic phages. The overall relative frequency of isolated bacteriophages lytic to subsp. necrophorum was significantly higher in city sewage than in ruminal fluid samples. The detection and isolation raises the possibility that lytic bacteriophages may have an application for use to eliminate or significantly reduce the concentrations of subsp. necrophorum in the rumens of feedlot cattle. The application suggests a novel intervention strategy and could eliminate the use of antibiotic in the feed to reduce the incidence of liver abscesses in feedlot cattle. Further investigation is warranted to conduct in vitro and or in vivo studies to assess phage survival and activity against subsp. necrophorum in the rumen.
Author Contributions
Conceptualization, V.V., D.U.T. and T.G.N.; methodology, V.V., T.G.N. and B.B.; formal analysis, V.V. and T.G.; investigation, S.E.S. and A.D.; resources, V.V. and T.G.N.; data curation, S.E.S., V.V. and T.G.; writing—original draft preparation, S.E.S. and A.D.; writing—review and editing, V.V. and T.G.N.; supervision, V.V. and T.G.N.; project administration, V.V. and T.G.N.; funding acquisition, V.V. All authors have read and agreed to the published version of the manuscript.
Funding
This research was funded by USDA NIFA 2019-67030-29706.
Institutional Review Board Statement
Not applicable.
Informed Consent Statement
Not applicable.
Data Availability Statement
Data are contained in the manuscript.
Acknowledgments
Contribution no. 24-252-J Kansas Agricultural Experiment Station, Manhattan. KS.
Conflicts of Interest
The authors declare no conflicts of interest. This article was prepared while Victoriya Volkova was employed at Kansas State University. The opinions expressed in this article are the authors’ own and do not reflect the view of the National Institutes of Health, the Department of Health and Human Services, or the United States government. The funders had no role in the design of the study; in the collection, analyses, or interpretation of data; in the writing of the manuscript; or in the decision to publish the results.
References
- Eastwood, L.C.; Boykin, C.A.; Harris, M.K.; Arnold, A.N.; Hale, D.S.; Kerth, C.R.; Griffin, D.B.; Savell, J.W.; Belk, K.E.; Woerner, D.R.; et al. National Beef Quality Audit-2016: Transportation, mobility, and harvest-floor assessments of targeted characteristics that affect quality and value of cattle, carcasses, and by-products. Trans. Anim. Sci. 2017, 1, 229–238. [Google Scholar] [CrossRef] [PubMed]
- Nagaraja, T.G.; Lechtenberg, K.F. Liver Abscesses in Feedlot Cattle. Vet. Clin. N. Am. Food Anim. Pract. 2007, 23, 351–369. [Google Scholar] [CrossRef] [PubMed]
- Langworth, B.F. Fusobacterium necrophorum: Its characteristics and role as an animal pathogen. Bacteriol. Rev. 1977, 41, 373–379. [Google Scholar] [CrossRef] [PubMed]
- Tadepalli, S.; Narayanan, S.K.; Stewart, G.C.; Chengappa, M.M.; Nagaraja, T.G. Fusobacterium necrophorum: A ruminal bacterium that invades the liver to cause abscesses in cattle. Anaerobe 2009, 15, 36–43. [Google Scholar] [CrossRef]
- Amachawadi, R.G.; Nagaraja, T.G. Pathogenesis of liver abscesses in cattle. Vet. Clin. N. Am. Food Anim. Pract. 2022, 38, 335–346. [Google Scholar] [CrossRef]
- Loh, B.; Gondil, V.S.; Manohar, P.; Khan, F.M.; Yang, H.; Leptihn, S. Encapsulation and delivery of therapeutic phages. Appl. Environ. Microbiol. 2021, 87, e01979-20. [Google Scholar] [CrossRef]
- Czaplewski, L.; Bax, R.; Clokie, M.; Dawson, M.; Fairhead, H.; Fischetti, V.A.; Foster, S.; Gilmore, B.F.; Hancock, R.E.W.; Harper, D.; et al. Alternatives to antibiotics—A pipeline portfolio review. Lancet Infect. Dis. 2016, 16, 239–251. [Google Scholar] [CrossRef]
- Gadde, U.; Kim, W.H.; Oh, S.T.; Lillehoj, H.S. Alternatives to antibiotics for maximizing growth performance and feed efficiency in poultry: A review. Anim. Health Res. Rev. 2017, 18, 26–45. [Google Scholar] [CrossRef]
- Fischetti, V. Development of phage lysins as novel therapeutics: A historical perspective. Viruses 2018, 10, 310. [Google Scholar] [CrossRef]
- Bruce, R.L.; James, J.B. Population and evolutionary dynamics of phage therapy. Nat. Rev. Microbiol. 2004, 2, 166–173. [Google Scholar] [CrossRef]
- Housby, J.N.; Mann, N.H. Phage therapy. Drug Discov. Today 2009, 14, 536–540. [Google Scholar] [CrossRef] [PubMed]
- Bhardwaj, N.; Bhardwaj, S.K.; Deep, A.; Dahiya, S.; Kapoor, S. Lytic bacteriophages as biocontrol agents of food-borne pathogens. Asian J. Anim. Vet. Adv. 2015, 10, 708–723. [Google Scholar] [CrossRef]
- Tamada, H.; Harasawa, R.; Shinjo, T. Isolation of a bacteriophage in Fusobacterium necrophorum. Nihon Juigaku Zasshi. Jpn. J. Vet. Sci. 1985, 47, 483. [Google Scholar] [CrossRef] [PubMed]
- Andrews, D.M.; Gharbia, S.E.; Shah, H.N. Characterization of a novel bacteriophage in Fusobacterium varium. Clin. Infect. Dis. 1997, 25 (Suppl. S2), S287–S288. [Google Scholar] [CrossRef][Green Version]
- Machuca, P.; Daille, L.; Vinés, E.; Berrocal, L.; Bittner, M. Isolation of a novel bacteriophage specific for the periodontal pathogen Fusobacterium nucleatum. Appl. Environ. Microbiol. 2010, 76, 7243–7350. [Google Scholar] [CrossRef]
- Amachawadi, R.G.; Purvis, T.J.; Lubbers, B.V.; Homm, J.W.; Maxwell, C.L.; Nagaraja, T.G. Bacterial flora of liver abscesses in crossbred beef cattle and Holstein steers fed finishing diets with or without tylosin. J. Anim. Sci. 2017, 95, 3425–3434. [Google Scholar] [CrossRef]
- Russell, J.B. Factors affecting lysine degradation by ruminal fusobacteria. FEMS Microbiol. Ecol. 2006, 56, 18–24. [Google Scholar] [CrossRef]
- Abedon, S.T.; Yin, J. Bacteriophage plaques: Theory and analysis. Methods Mol. Biol. 2009, 501, 161–174. [Google Scholar] [CrossRef] [PubMed]
- Gingerich, D.A.; Baggot, J.D.; Kowalski, J.J. Tylosin antimicrobial activity and pharmacokinetics in cows. Can. Vet. J. 1977, 18, 96–100. [Google Scholar]
- Tan, Z.L.; Nagaraja, T.G.; Chengappa, M.M. Biochemical and biological characterization of ruminal Fusobacterium necrophorum. FEMS Microbiol. Lett. 1994, 120, 81–86. [Google Scholar] [CrossRef]
- Lechtenberg, K.F.; Nagaraja, T.G.; Chengappa, M.M. Antimicrobial susceptibility of Fusobacterium necrophorum isolated from bovine hepatic abscesses. Am. J. Vet. Res. 1998, 59, 44–47. [Google Scholar] [CrossRef] [PubMed]
- Scott, H.M.; Acuff, G.; Bergeron, G.; Bourassa, M.W.; Gill, J.; Graham, D.W.; Kahn, L.H.; Morley, P.S.; Salois, M.J.; Simjee, S.; et al. Critically important antibiotics: Criteria and approaches for measuring and reducing their use in food animal agriculture. Annal. N. Y. Acad. Sci. 2019, 1441, 8–16. [Google Scholar] [CrossRef]
- FDA, U.S. Veterinary Feed Directive. Available online: https://www.fda.gov/animal-veterinary/development-approval-process/veterinary-feed-directive-vfd (accessed on 24 January 2025).
- Zaheer, R.; Cook, S.R.; Klima, C.L.; Stanford, K.; Alexander, T.; Topp, E.; Read, R.R.; McAllister, T.A. Effect of sub-therapeutic vs. therapeutic administration of macrolides on antimicrobial resistance in Mannheimia haemolytica and enterococci isolated from beef cattle. Front. Microbiol. 2013, 4, 133. [Google Scholar] [CrossRef] [PubMed]
- Beukers, A.G.; Zaheer, R.; Cook, S.R.; Stanford, K.; Chaves, A.V.; Ward, M.P.; McAllister, T.A. Effect of in-feed administration of tylosin phosphate on antibiotic resistance in enterococci isolated from feedlot steers. Front. Microbiol. 2015, 6, 483. [Google Scholar] [CrossRef] [PubMed]
- Müller, H.C.; Van Bibber-Krueger, C.L.; Ogunrinu, O.J.; Amachawadi, R.G.; Scott, H.M.; Drouillard, J.S. Effects of intermittent feeding of tylosin phosphate during the finishing period on feedlot performance, carcass characteristics, antimicrobial resistance, and incidence and severity of liver abscesses in steers. J. Anim. Sci. 2018, 96, 2877–2885. [Google Scholar] [CrossRef] [PubMed]
- Schmidt, J.W.; Vikram, A.; Miller, E.; Jones, S.A.; Arthur, T.M. In-feed tylosin phosphate administration to feedlot cattle minimally affects antimicrobial resistance. J. Food Protect. 2020, 83, 350–364. [Google Scholar] [CrossRef]
- Nagaraja, T.G.; Beharka, A.B.; Chengappa, M.M.; Carroll, L.H.; Raun, A.P.; Laudert, S.B.; Parrott, J.C. Bacterial flora of liver abscesses in feedlot cattle fed tylosin or no tylosin. J. Anim. Sci. 1999, 77, 973–978. [Google Scholar] [CrossRef]
- Saginala, S.; Nagaraja, T.G.; Lechtenberg, K.F.; Chengappa, M.M.; Kemp, K.E.; Hine, P.M. Effect of Fusobacterium necrophorum leukotoxoid vaccine on susceptibility to experimentally induced liver abscesses in cattle. J. Anim. Sci. 1997, 75, 1160–1166. [Google Scholar] [CrossRef]
- Jones, G.; Jayappa, H.; Hunsaker, B.; Sweeney, D.; Rapp-Gabrielson, V.; Woesman, T.; Nagaraja, T.G.; Swingle, S.; Branine, M. Efficacy of an Arcanobacterium pyogenes-Fusobacterium necrophorum bacterin-toxoid as an aid in the prevention of liver abscesses in cattle. Bovine Pract. 2004, 38, 36–44. [Google Scholar] [CrossRef]
- Fox, J.T.; Thomson, D.U.; Lindberg, N.N.; Barling, K. A Comparison of two vaccines to reduce liver abscesses in natural-fed beef cattle. Bovine Pract. 2009, 43, 168–174. [Google Scholar] [CrossRef]
- Meyer, N.F.; Erickson, G.E.; Klopfenstein, T.J.; Greenquist, M.A.; Luebbe, M.K.; Williams, P.; Engstrom, M.A. Effect of essential oils, tylosin, and monensin on finishing steer performance, carcass characteristics, liver abscesses, ruminal fermentation, and digestibility. J. Anim. Sci. 2009, 87, 2346–2354. [Google Scholar] [CrossRef] [PubMed]
- Elwakeel, E.A.; Amachawadi, R.G.; Nour, A.M.; Nasser, M.E.A.; Nagaraja, T.G.; Titgemeyer, E.C. In vitro degradation of lysine by ruminal fluid-based fermentations and by Fusobacterium necrophorum. J. Dairy Sci. 2013, 96, 495–505. [Google Scholar] [CrossRef]
- Samii, S.S.; Wallace, N.; Nagaraja, T.G.; Engstrom, M.A.; Miesner, M.D.; Armendariz, C.K.; Titgemeyer, E.C. Effects of limonene on ruminal Fusobacterium necrophorum concentrations, fermentation, and lysine degradation in cattle. J. Anim. Sci. 2016, 94, 3420–3430. [Google Scholar] [CrossRef]
- Mir, P.S.; Dugan, M.E.R.; He, M.L.; Entz, T.; Yip, B. Effects of dietary sunflower seeds and tylosin phosphate on production variables, carcass characteristics, fatty acid composition, and liver abscess incidence in crossbred steers. J. Anim. Sci. 2008, 86, 3125–3136. [Google Scholar] [CrossRef]
- Stotz, M.K.; Henry, D.D.; Crossland, W.L. Evaluation of immunoglobulin-Y in place of tylosin phosphate in the diets fed to Holstein steers and preliminary analysis of liver abscess duration on animal growth performance. Trans. Anim. Sci. 2021, 5, 1–12. [Google Scholar] [CrossRef]
- Huebner, K.L.; Martin, J.N.; Weissend, C.J.; Holzer, K.L.; Parker, J.K.; Lakin, S.M.; Doster, E.; Weinroth, M.D.; Abdo, Z.; Woerner, D.R.; et al. Effects of a Saccharomyces cerevisiae fermentation product on liver abscesses, fecal microbiome, and resistome in feedlot cattle raised without antibiotics. Sci. Rep. 2019, 9, 2559. [Google Scholar] [CrossRef]
- Amachawadi, R.G.; Nagaraja, T.G. Liver abscesses in cattle: A review of incidence in Holsteins and of bacteriology and vaccine approaches to control in feedlot cattle. J. Anim. Sci. 2016, 94, 1620–1632. [Google Scholar] [CrossRef]
- Checkley, S.L.; Janzen, E.D.; Campbell, J.; McKinnon, J.J. Efficacy of vaccination against Fusobacterium necrophorum infection for control of liver abscesses and footrot in feedlot cattle in western Canada. Can. Vet. J. 2005, 46, 1002–1007. [Google Scholar]
- Shen, Y.; Taylor, D.; Tao, R.; Saleem, A.M.; Yoon, I.; Narvaez, C.; McAllister, T.A.; Yang, W. Ruminally protected and unprotected Saccharomyces cerevisiae fermentation products as alternatives to antibiotics in finishing beef steers. J. Anim. Sci. 2019, 97, 4323–4333. [Google Scholar] [CrossRef]
- Shen, Y.; Wang, H.; Ran, T.; Yoon, I.; Saleem, A.M.; Yang, W. Influence of yeast culture and feed antibiotics on ruminal fermentation and site and extent of digestion in beef heifers fed high grain rations. J. Anim. Sci. 2018, 96, 3916–3927. [Google Scholar] [CrossRef]
- Gordillo Altamirano, F.L.; Barr, J.J. Phage therapy in the postantibiotic era. Clin. Microbiol. Rev. 2019, 32, e00066. [Google Scholar] [CrossRef] [PubMed]
- Liu, D.; Van Belleghem, J.D.; de Vries, C.R.; Burgener, E.; Chen, Q.; Manasherob, R.; Aronson, J.R.; Amanatullah, D.F.; Tamma, P.D.; Suh, G.A. The safety and toxicity of phage therapy: A review of animal and clinical studies. Viruses 2021, 13, 1268. [Google Scholar] [CrossRef] [PubMed]
- Summers, W.C. The strange history of phage therapy. Bacteriophage 2012, 2, 130–133. [Google Scholar] [CrossRef] [PubMed]
- Joerger, R.D. Alternatives to antibiotics: Bacteriocins, antimicrobial peptides, and bacteriophages. Poultry Sci. 2003, 82, 640–647. [Google Scholar] [CrossRef]
- Matsuzaki, S.; Rashel, M.; Uchiyama, J.; Sakurai, S.; Ujihara, T.; Kuroda, M.; Ikeuchi, M.; Tani, T.; Fujieda, M.; Wakiguchi, H.; et al. Bacteriophage therapy: A revitalized therapy against bacterial infectious diseases. J. Infect. Chemother. 2005, 11, 211–219. [Google Scholar] [CrossRef]
- Kutateladze, M.; Adamia, R. Bacteriophages as potential new therapeutics to replace or supplement antibiotics. Trends Biotechnol. 2010, 28, 591–595. [Google Scholar] [CrossRef]
- Ghosh, C.; Sarkar, P.; Issa, R.; Haldar, J. Alternatives to conventional antibiotics in the era of antimicrobial resistance. Trends Microbiol. 2019, 27, 323–338. [Google Scholar] [CrossRef]
- Saha, D.; Mukherjee, R. Ameliorating the antimicrobial resistance crisis: Phage therapy. IUBMB Life 2019, 71, 781–790. [Google Scholar] [CrossRef]
- Russell, J.B. Enrichment of fusobacteria from the rumen that can utilize lysine as an energy source for growth. Anaerobe 2005, 11, 177–184. [Google Scholar] [CrossRef]
- Szafrański, S.P.; Winkel, A.; Stiesch, M. The use of bacteriophages to biocontrol oral biofilms. J. Biotechnol. 2017, 250, 29–44. [Google Scholar] [CrossRef]
- Zheng, D.W.; Dong, X.; Pan, P.; Chen, K.W.; Fan, J.X.; Cheng, S.X.; Zhang, X.Z. Phage-guided modulation of the gut microbiota of mouse models of colorectal cancer augments their responses to chemotherapy. Nat. Biomed. Eng. 2019, 3, 717–728. [Google Scholar] [CrossRef] [PubMed]
- Kristensen, L.H.; Prag, J. Human necrobacillosis, with emphasis on Lemierre’s syndrome. Clin. Infect. Dis. 2000, 31, 524–532. [Google Scholar] [CrossRef] [PubMed]
- Amess, J.A.; O’Neill, W.; Ni Giollariabhaigh, C.; Dytrych, J.K. A six-month audit of the isolation of Fusobacterium necrophorum from patients with sore throat in a district general hospital. Brit. J. Biomed. Sci. 2007, 64, 63–65. [Google Scholar] [CrossRef] [PubMed]
- Kuppalli, K.; Livorsi, D.; Talati, N.J.; Osborn, M. Lemierre’s syndrome due to Fusobacterium necrophorum. Lancet Infect. Dis. 2012, 12, 808–815. [Google Scholar] [CrossRef] [PubMed]
- Eaton, C.; Swindells, J. The significance and epidemiology of Fusobacterium necrophorum in sore throats. J. Infect. 2014, 69, 194–196. [Google Scholar] [CrossRef]
- Holm, K.; Collin, M.; Hagelskjær-Kristensen, L.; Jensen, A.; Rasmussen, M. Three variants of the leukotoxin gene in human isolates of Fusobacterium necrophorum subspecies funduliforme. Anaerobe. 2017, 45, 129–132. [Google Scholar] [CrossRef]
- Tadepalli, S.; Stewart, G.C.; Nagaraja, T.G.; Narayanan, S.K. Human Fusobacterium necrophorum strains have a leukotoxin gene and exhibit leukotoxic activity. J. Med. Microbiol. 2008, 57, 225–231. [Google Scholar] [CrossRef][Green Version]
- Ballesté, E.; Blanch, A.R.; Muniesa, M.; García-Aljaro, C.; Rodríguez-Rubio, L.; Martín-Díaz, J.; Pascual-Benito, M.; Jofre, J. Bacteriophages in sewage: Abundance, roles, and applications. FEMS Microbes 2022, 17, xtac009. [Google Scholar] [CrossRef]
Disclaimer/Publisher’s Note: The statements, opinions and data contained in all publications are solely those of the individual author(s) and contributor(s) and not of MDPI and/or the editor(s). MDPI and/or the editor(s) disclaim responsibility for any injury to people or property resulting from any ideas, methods, instructions or products referred to in the content. |
© 2025 by the authors. Licensee MDPI, Basel, Switzerland. This article is an open access article distributed under the terms and conditions of the Creative Commons Attribution (CC BY) license (https://creativecommons.org/licenses/by/4.0/).